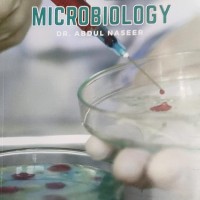
Microbiology  E gurukul 3.0 Colored Notes by DBMCI

Model: SGCg0522825
Medicine Handwritten Alpha Notes 2025 By Dams.Total No. of Pages 521..
Rs.1,431.00 Rs.1,700.00
Ex Tax:Rs.1,431.00
Model: SGCg03
In its fourth edition, this book incorporates the recent advances in medicine as well as my personal insights on how to learn better. Based on earlier and the 19th edition of Harrisons Principles of Internal Medicine, published by The McGraw-Hill Companies, Inc., this book also comprises relevant st..
Rs.548.00 Rs.895.00
Ex Tax:Rs.548.00
Model: SGCi14
Medicine Notes color 2024 for NEET SS.It Contains Following Subjects :1. General Medicine2. Cardiology3. Neurology4. Gastroenterology5. Hepatology6. Infectious Diseases7. Nephrology 8. Endocrinology 9. Hematology 10. Pediatrics 11. Rheumatology 12. Oncology ..
Rs.21,500.00 Rs.32,000.00
Ex Tax:Rs.21,500.00
Model: SGBf118SGCa87
Medicine Prep Manual 5th edition For Undergraduates by K George Mathew ..
Rs.605.00 Rs.1,075.00
Ex Tax:Rs.605.00
Model: SGCf47
About the Book: Medicine: Prep Manual For UndergraduatesWith ever-expanding knowledge and advances in medicine, the sixth edition of this book is significantly revised and presented in new full-colour format. Structured in question-answer format, this book is a must-have for all undergraduate medica..
Rs.590.00 Rs.1,050.00
Ex Tax:Rs.590.00
Model: SGCc71
Methods in Biostatistics : For Medical Students and Research Workers by BK Mahajan..
Rs.158.00 Rs.395.00
Ex Tax:Rs.158.00
Model: SGBf163
Microbiology E gurukul 3.0 Colored Notes by DBMCI is useful for NEET PG also for various competitive exams.Total No. of Pages-184..
Rs.1,100.00 Rs.1,500.00
Ex Tax:Rs.1,100.00
Model: SGCc48
Microbiology in Nutshell 2nd Edition By CP Baveja..
Rs.153.00 Rs.375.00
Ex Tax:Rs.153.00
Model: SGCa87
Microbiology Mirror by Dr. Ronak N Desai..
Rs.80.00 Rs.180.00
Ex Tax:Rs.80.00
Model: SGCg71
Under the new Competency Based Undergraduate Curriculum for the Indian Medical Graduate, the MBBS students in Phase II require training different from the traditional and conventional methods to a system based teaching module. The primary aim of this practical manual is to assist MBBS students to sp..
Rs.270.00 Rs.525.00
Ex Tax:Rs.270.00
Model: SGCh85
Mudaliar and Menon’s Clinical Obstetrics, a classic among textbooks, has been popular with several generations of students. Originally written by Dr A.L. Mudaliar and Dr. M.K. Krishna Menon, the twelfth edition has been thoroughly updated and revised to keep abreast of the latest advances in obstetr..
Rs.538.00 Rs.1,195.00
Ex Tax:Rs.538.00
Model: SGBa202
First of its kind when the book is not written by the senior authors but by the student who is in the race of PGMEE competition. Being the student ourselves, we have observed that giving sleepless nights to textbooks, class notes and question-based books, studying the whole year but failing to compi..
Rs.540.00 Rs.1,195.00
Ex Tax:Rs.540.00
Model: SGCi170
Book DescriptionFrank Netter’s Atlas of Human Anatomy is a complete reference for students of medical sciences. It helps students understand the complete framework of the Human Body, giving them detailed explanations about the structure, methods used to study them and common ailments...
Rs.1,225.00 Rs.2,537.00
Ex Tax:Rs.1,225.00
Model: SGCg43
Neurological Examination in Clinical Practice 5th Edition by Edwin R Bickerstaff..
Rs.158.00 Rs.245.00
Ex Tax:Rs.158.00
Model: SGCc98
NEW SARP SERIES FOR NEET NBE AI REVISE ANATOMY 4th Edition by K Raviraj ..
Rs.483.00 Rs.1,050.00
Ex Tax:Rs.483.00
Model: SGCg49
Nosocomial Pneumonia Strategies for Management by Editor Jordi Rello..
Rs.520.00 Rs.1,000.00
Ex Tax:Rs.520.00